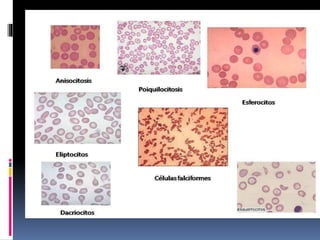

La anemia aplásica se caracteriza por una disminución de la producción de los tres tipos principales de células sanguíneas (glóbulos rojos, glóbulos blancos y plaquetas) debido a una insuficiencia de la médula ósea. Esto puede deberse a causas adquiridas como radiación, fármacos o infecciones virales, o causas hereditarias como la enfermedad de Fanconi. Los síntomas incluyen palidez, fatiga, hemorragias e infecciones. El diagnóstico se